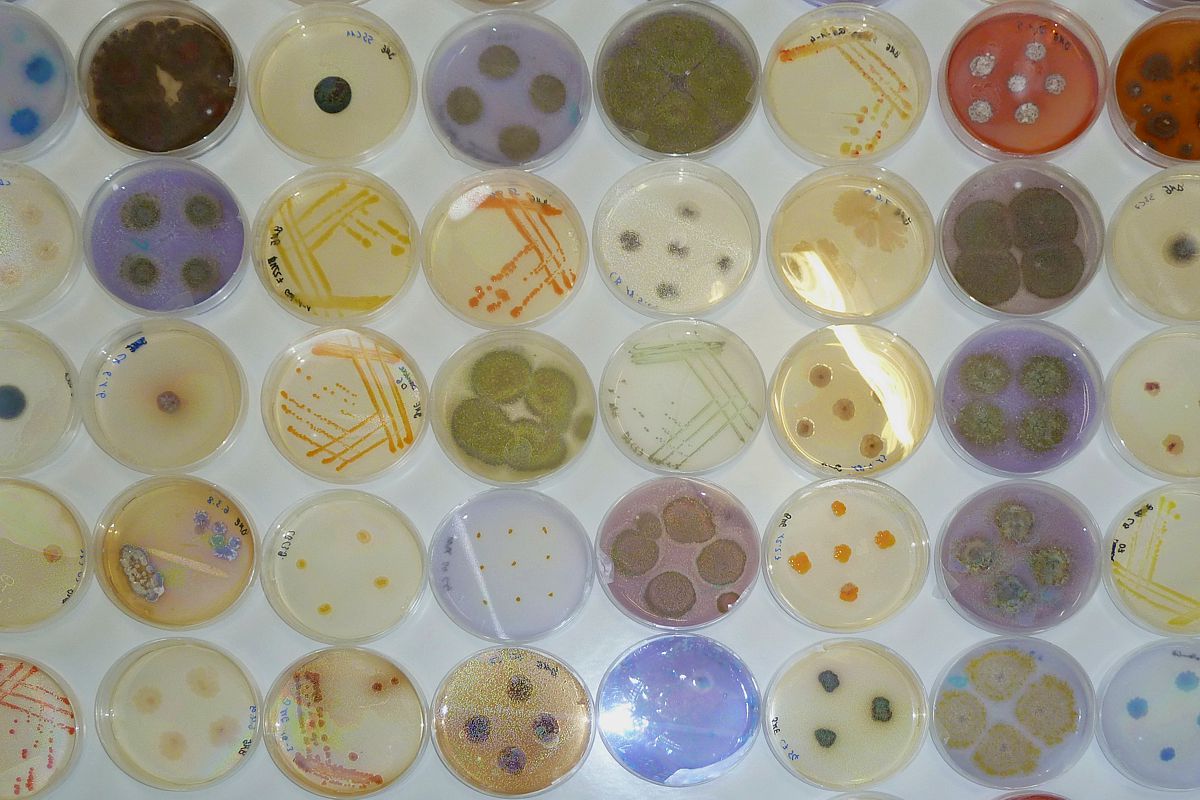
Diversity of soil bacteria and fungi. Photo: Thomas Reitz/UFZ

Research Field:
Structural & Functional Biodiversity
Soil, litter or dead wood represent complex and heterogeneous habitats for all types of below ground organisms (i.e. algae, animals and microorganisms). Our department mainly investigates bacteria and fungi, which apart contribution the largest part of the below ground biomass, also display a broad range of functions and lifestyles such as saprotrophs, mutualistic or detrimental symbionts.
The structural and functional diversity of soil microbes is extremely high, but only 1 % of them can currently be grown under laboratory conditions. In the last decades the development of diverse molecular methods and in particular next-generation sequencing and the taxonomical or functional assignments of microorganisms by use of customized databases prompted the exploration the soil microbial diversity and its link to functions.
The department combines traditional cultivation methods with modern molecular techniques to unravel the structural and functional soil microbial diversity in relation to land use, above ground biodiversity and climatic context.